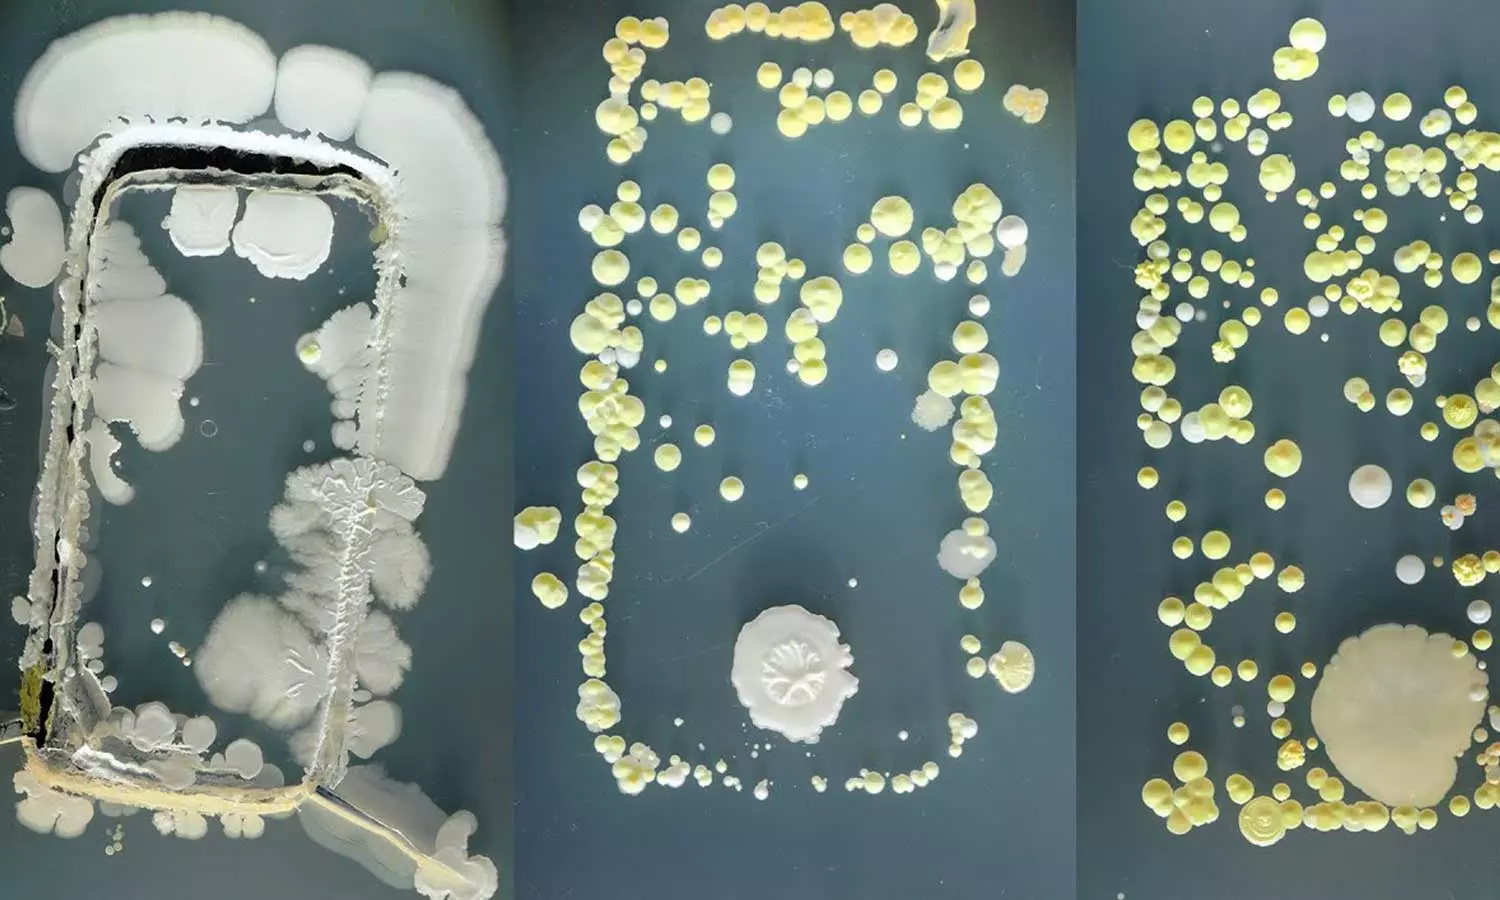

മൊബൈൽ ഫോണിലുണ്ട്, പൊതു ടോയ്ലെറ്റിലും പത്തിരട്ടി അണുക്കൾ-മുന്നറിയിപ്പ്
|മൊബൈൽ ഫോണുകൾ അണുമുക്തമായി സൂക്ഷിക്കാനുള്ള മാര്ഗവും ആരോഗ്യ വിദഗ്ധർ പറയുന്നുണ്ട്
ന്യൂയോർക്ക്: രാവിലെ ഉറക്കമുണരുന്നതുതൊട്ട് രാത്രി ഉറങ്ങുന്നതുവരെ മൊബൈൽ ഫോൺ മാറ്റിവച്ചൊരു ജീവിതത്തെക്കുറിച്ച് ആലോചിക്കാൻ കഴിയുമോ നിങ്ങൾക്ക്!? മൊബൈൽ ഫോൺ അത്രയും ഭീകരമായി നമ്മുടെ നിത്യജീവിതത്തിന്റെ ഭാഗമായി മാറിയിട്ടുണ്ട്. എന്നാൽ, വൻ ആരോഗ്യപ്രശ്നങ്ങൾ വിളിച്ചുവരുത്താൻ മാത്രം അണുക്കൾ ഫോണിനുമേലുണ്ടെന്നു പറഞ്ഞാൽ വിശ്വസിക്കാനാകുമോ? ഇല്ലെങ്കിൽ, വിശ്വസിച്ചോളൂ, പൊതുകക്കൂസിലുള്ളതിലും കൂടുതൽ ബാക്ടീരിയകൾ പലപ്പോഴും മൊബൈൽ ഫോൺ വഹിക്കുന്നുണ്ടാകാനിടയുണ്ടെന്നാണ് പുതിയൊരു പഠനം.
യു.എസിലെ ല്യൂസിയാന കേന്ദ്രമായുള്ള ത്വക്ക്രോഗ വിദഗ്ധയും ആരോഗ്യസംബന്ധമായ വിഡിയോകളിലൂടെ ടിക്ടോക്കിലും ഇൻസ്റ്റഗ്രാമിലും താരവുമായ മാമിന ട്യുറേഗാനോയാണ് മൊബൈൽ ഫോണുകളിലെ ബാക്ടീരിയകളെക്കുറിച്ച് വെളിപ്പെടുത്തിയിരിക്കുന്നത്. പൊതുബാത്റൂമിനെക്കാളും, ചിലപ്പോൾ പൊതു കക്കൂസിനെക്കാളും അണുക്കൾ നിറഞ്ഞതായിരിക്കും സ്ഥിരം ഉപയോഗത്തിലുള്ള മൊബൈൽ ഫോണെന്നാണ് അവർ പറയുന്നത്. പുതിയ പഠനങ്ങളെ ഉദ്ധരിച്ചാണ് അവർ ഇക്കാര്യം വിശദീകരിക്കുന്നത്.
കൗമാരക്കാരുടെ മൊബൈൽ ഫോണുകളിൽ ഒരേസമയം ചുരുങ്ങിയത് 17,000ത്തോളം അണുക്കളുണ്ടാകുമെന്ന് അടുത്തിടെ അരിസോണ സർവകലാശാലയിലെ ഒരു സംഘം ഗവേഷകർ കണ്ടെത്തിയിരുന്നു. ഇത് പൊതു ടോയ്ലെറ്റുകളിലുണ്ടാകുന്ന അണുക്കളുടെ പത്തിരട്ടി വരുമെന്നാണ് പഠനത്തിൽ പറയുന്നത്. മൊബൈൽ ഫോണുമായി ടോയ്ലെറ്റുകളിൽ പോകുന്നതും അഴുക്കുള്ള സ്ഥലങ്ങളിൽ വയ്ക്കുന്നതുമെല്ലാം അണുബാധയ്ക്കിടയാക്കും.
ഈ ഫോണാണ് സാധാരണ പോലെ കൈയിൽ കൊണ്ടുനടക്കുന്നത്. കോളുകൾ വരുമ്പോൾ മുഖത്തോട് ചേർത്തുപിടിക്കുകയും ചെയ്യും. പലതരത്തിലുള്ള ത്വക്ക്രോഗങ്ങളാണ് ഇതു വിളിച്ചുവരുത്തുക. ഇതോടൊപ്പം മറ്റ് ഗുരുതര അസുഖങ്ങൾക്കും ഇടയാക്കിയേക്കുമെന്ന് ആരോഗ്യവിദഗ്ധർ മുന്നറിയിപ്പ് നൽകുന്നു.
മൊബൈൽ ഫോണുകൾ അണുമുക്തമായി സൂക്ഷിക്കാനുള്ള വഴികളും മാമിന ട്യുറേഗാനോ പറയുന്നുണ്ട്. ഫോൺ ഇടയ്ക്കിടയ്ക്ക് വൃത്തിയാക്കുക തന്നെയാണ് പ്രധാന മാർഗം. ചെറുതായി നനവുള്ള തുണി ഉപയോഗിച്ച് തുടക്കാം. സോപ്പ് കലക്കിയ വെള്ളത്തിൽ തുണി മുക്കി ചെറിയ നനവോടെ ഫോൺ വൃത്തിയാക്കാം. അണുക്കളെ ഇല്ലായ്മ ചെയ്യാവുന്ന മറ്റ് ദ്രാവകങ്ങളും ഉപയോഗിക്കാമെന്നാണ് അവർ പറയുന്നത്.
Summary: Mobile phones contain more bacteria than public toilets: Study reveals